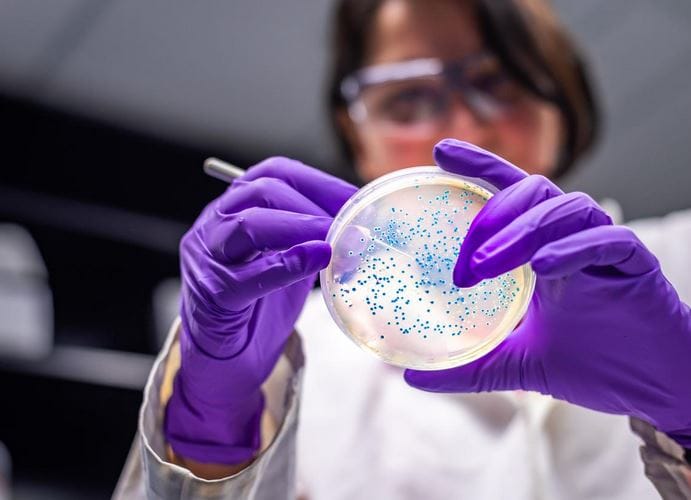

Selon un nouveau rapport du Programme des Nations Unies pour l’environnement (PNUE), les Nations Unies lancent une alerte contre l’apparition et la propagation des supebactéries résistantes aux antibiotiques à cause de la crise climatique. Extension du domaine de la pesnée magique.